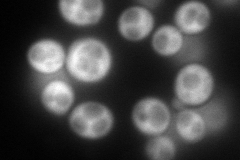
YDR127W
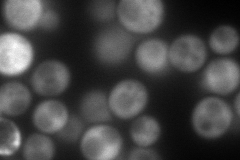
YDR127W
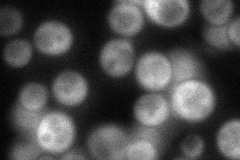
YDR127W
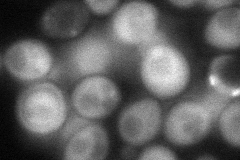
YDR127W
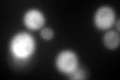
YDR127W
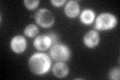
YDR127W
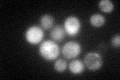
YDR127W

View description
Pentafunctional arom protein, catalyzes steps 2 through 6 in the biosynthesis of chorismate, which is a precursor to aromatic amino acids
Localization:
Intensity:
Fold change:
Significance:
-
C’ GFP library in SD

cytosol154.26 -
N' NOP1pr-GFP in SD
cytosol275.079 -
N' TEF2pr-mCherry in SD
cytosol192.005 -
N' NATIVEpr-GFP in SD
cytosol85.7207 -
N' TEF2pr-VC and Cyto-VN in SD
cytosol80.4737 -
C’ GFP library in SD+DTT
cytosol125.610.81No -
C’ GFP library in SD+H2O2
cytosol157.241.01No -
C’ GFP library in Starvation Media
cytosol97.130.62No -
C’ GFP library on the background of Pup2-DaMP

cytosol -
C’ GFP library on the background of CCT mutant

cytosol169.8251.10079No
